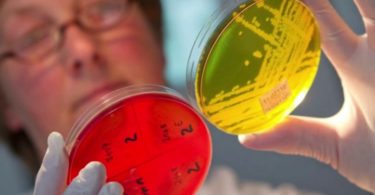

Балантидиаз — это инфекционное паразитарное заболевание, второе название которого — инфузорная дизентерия. Данная болезнь вызывается простейшей инфузорией Balantidium соli. Впервые возбудитель балантидиаза был описан в 1857, а в 1901 г...
Болезни от паразитов
Если появилось ощущение как будто в заднем проходе шевеление
Возникающее впервые ощущение в заднем проходе как будто шевеление заставляет человека задуматься о причинах его возникновения. Появившееся щекотание не устраняется после попыток почесать проблемную область, а иногда даже усиливается. Данный симптом...
Каким должно быть лечение трихомониаза: препараты и схема
Для лечения трихомониаза у женщин препараты, схема их приема — все это должно назначаться только врачом, и тщательно соблюдаться пациентом. Трихомониаз — опасное заболевание, передающееся половым путем. Если его не лечить, то патология...
Лечение энтеробиоза у детей и взрослых
Энтеробиоз очень распространен, поэтому каждый взрослый человек обязан знать, каким должно быть лечение энтеробиоза у взрослых и у детей. В медицине энтеробиозом называют заболевание, которое возникает впоследствии заражения человека глистами остриц...
Каковы симптомы клонорхоза и его лечение
Если некачественно термически обработать рыбу, то можно заполучить заболевание клонорхоз. Как и все гельминты, у этого подвида нет выраженной симптоматики. Пациенты способны носить в себе клубки паразитов и не знать об этом. Часто обращение к врачу...
Как заражаются лейшманиями: симптомы и лечение лейшманиоза
Лейшмания — это простой внутриклеточный паразит, который вызывает инфекционное заболевание под названием лейшманиоз, переносчики данных паразитов — москиты. Они заносятся в человеческий организм через укус зараженного комара или москита...
Чем опасен филяриоз: симптомы и лечение
В странах с тропическим климатом распространен филяриоз — это глистная инвазия, которую относят к группе нематодозов. Если просмотреть данные статистики, то по всему миру было инфицировано более 100 млн человек. При этом треть из них находится...
Симптомы и лечение эхинококкоза у человека
При эхинококкозе симптомы у человека проявляются по-разному в зависимости от стадии. Само заболевание относится к хроническим паразитарным, развивающееся в результате внедрения в организм личинок Echinococcus granulosus. Этот гельминт широко...